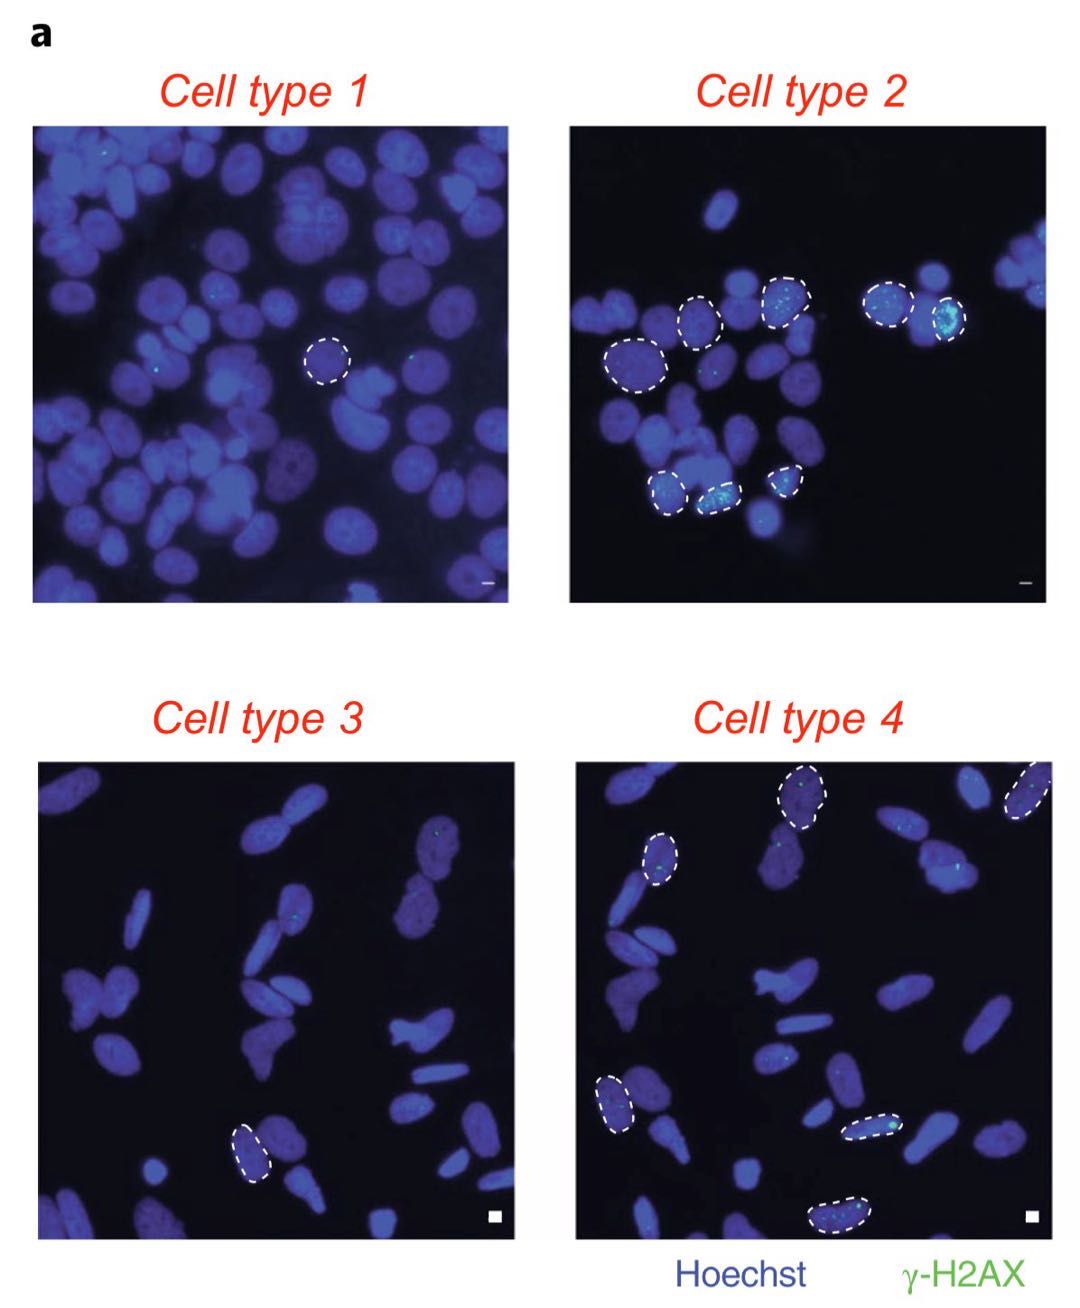
论文图片,论文图片造假,Elisabeth Bik
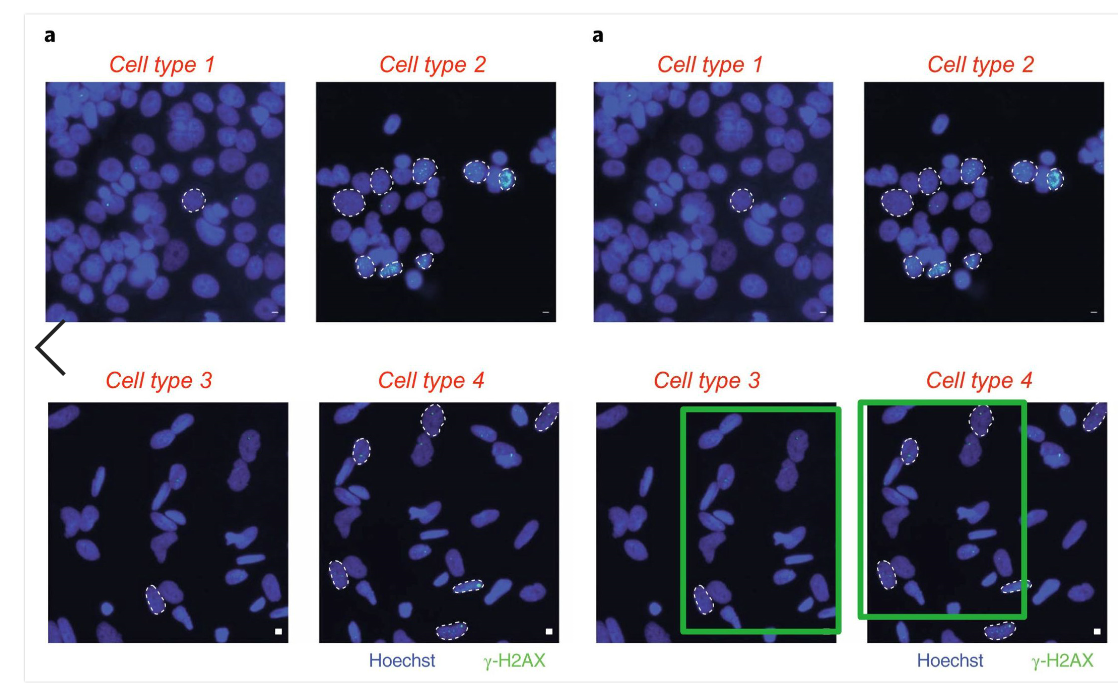

图片造假无处不在
只是缺少发现错误的眼睛
旋转、缩放大小、剪辑、亮度调整,模糊处理......这些PS技术虽好,但用错了地方那就是科学诚信问题了。

我们知道翔实的插图远胜万语千言(a picture is worth a thousand words),有些论文图片问题也许是honest mistake ,但有些却突破了底线,许多拥有丰富经验的期刊编辑或专业学者仅凭肉眼便能很快发现论文图片问题。
那么多图片怎么找啊?
目前,学术打假专业户Elisabeth Bik在自己的官方账号上发起了#ImageForensics话题,像是一种全民找茬的游戏,Elisabeth Bik发一张嫌疑图片让大家找存在的重复项,第一个猜对的将获得表情包奖励。

Elisabeth Bik
玩归玩,但没想到参与的人还不少,一些在知名期刊上已发表的论文也被发现疑似存在图片问题,并且成功引起了期刊主编的注意。
今天我们也一起来玩这样的图片找茬游戏,我们列举了Elisabeth Bik发布的6张嫌疑图片,答案我们放在文末,记住:答案采用的是Elisabeth Bik的解释,有些图片存在的问题可能不止答案中圈出的那些。考考你的眼里,看看哪些地方存在重复吧:
1

这是一张免疫组织化学图像(显微镜照片)。四列代表不同处理的大鼠。3排不同的蛋白质染色。所有面板“应”看起来不同(无二次染色)。查找重复项!
2

每个面板应看起来不同且独特,仔细查看不同的象限,看看图像是否有重复。
3
这张图的重复有点明显,很容易看出,每张照片都应该是独一无二的。此图是读者提供给Elisabeth Bik的,据说是在英美顶级研究研所的论文中发现的。
4

六幅尼可提亚树叶的图像,每幅都以不同的方式处理。你能找出两片看起来相似的叶子吗?这幅图难度比较大,达到图像鉴别专家级别。
5

这幅图就是小助手分享到朋友圈的那张,看到重复了吗?朋友圈的好友中可是有找到重复的朋友呢,厉害!Elisabeth Bik都差点没发现:“ I almost missed this one. But then I screamed.”
6

四个不同的流式细胞仪面板,每个代表不同的治疗组。有什么特别的发现吗?
找到重复了吗?
我可要公布答案了
1

2

3
4

5

6

都发现了?
即便发现一张图的重复项也很厉害了,基本具备打假功力!